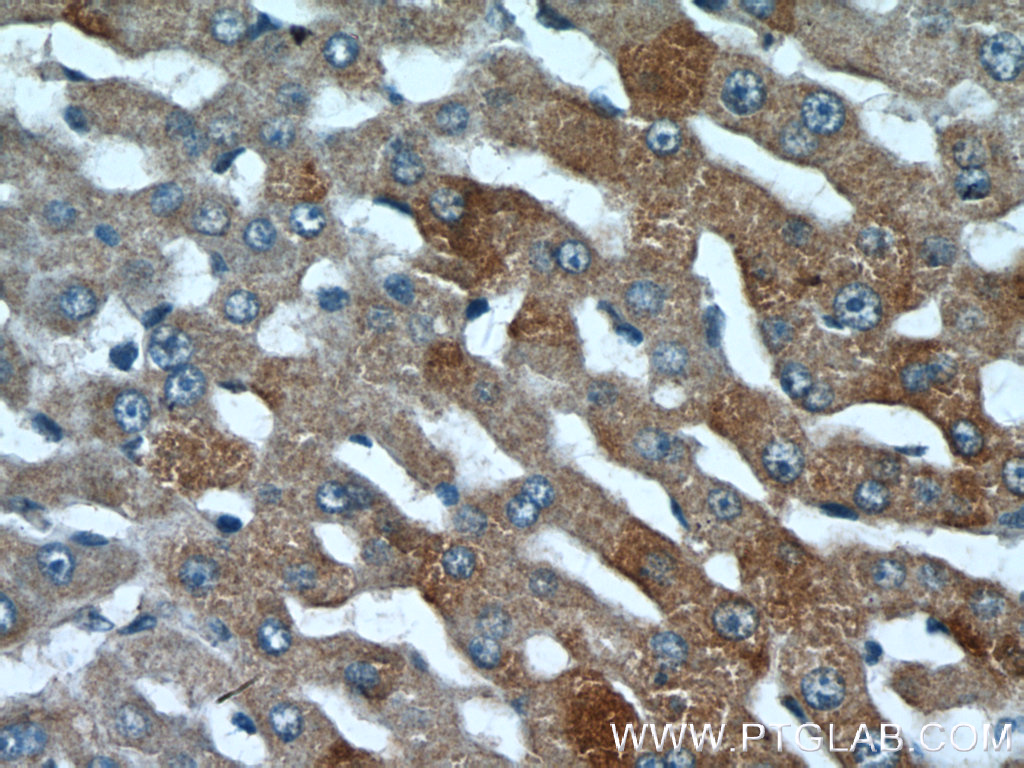

验证数据展示
经过测试的应用
| Positive WB detected in | HeLa cells, HEK-293 cells |
| Positive IP detected in | HEK-293 cells |
| Positive IHC detected in | human liver tissue Note: suggested antigen retrieval with TE buffer pH 9.0; (*) Alternatively, antigen retrieval may be performed with citrate buffer pH 6.0 |
| Positive IF/ICC detected in | HeLa cells |
推荐稀释比
| 应用 | 推荐稀释比 |
|---|---|
| Western Blot (WB) | WB : 1:1000-1:4000 |
| Immunoprecipitation (IP) | IP : 0.5-4.0 ug for 1.0-3.0 mg of total protein lysate |
| Immunohistochemistry (IHC) | IHC : 1:100-1:400 |
| Immunofluorescence (IF)/ICC | IF/ICC : 1:50-1:500 |
| It is recommended that this reagent should be titrated in each testing system to obtain optimal results. | |
| Sample-dependent, Check data in validation data gallery. | |
产品信息
21041-1-AP targets PML in WB, IHC, IF/ICC, IP, ELISA applications and shows reactivity with human samples.
| 经测试应用 | WB, IHC, IF/ICC, IP, ELISA Application Description |
| 文献引用应用 | WB, IHC, IF |
| 经测试反应性 | human |
| 文献引用反应性 | human, mouse |
| 免疫原 |
CatNo: Ag15377 Product name: Recombinant human PML protein Source: e coli.-derived, PGEX-4T Tag: GST Domain: 73-418 aa of BC020994 Sequence: LHTLCSGCLEASGMQCPICQAPWPLGADTPALDNVFFESLQRRLSVYRQIVDAQAVCTRCKESADFWCFECEQLLCAKCFEAHQWFLKHEARPLAELRNQSVREFLDGTRKTNNIFCSNPNHRTPTLTSIYCRGCSKPLCCSCALLDSSHSDLKCDISAEIQQRQEELDAMTQALQEQDSAFGAVHAQMHAAVGQLGRARAETEELIRERVRQVVAHVRAQERELLEAVDARYQRDYEEMASRLGRLDAVLQRIRTGSALVQRMKCYASDQEVLDMHGFLRQALCRLRQEEPQSLQAAVRTDGFDEFKVRLQDLSSCITQGKDAAVSKKASPEAASTPRDPIDVDL 种属同源性预测 |
| 宿主/亚型 | Rabbit / IgG |
| 抗体类别 | Polyclonal |
| 产品类型 | Antibody |
| 全称 | promyelocytic leukemia |
| 别名 | E3 SUMO-protein ligase PML, EC:2.3.2.-, Protein PML, RING-type E3 SUMO transferase PML, RNF71 |
| 计算分子量 | 882 aa, 98 kDa |
| 观测分子量 | 120 kDa |
| GenBank蛋白编号 | BC020994 |
| 基因名称 | PML |
| Gene ID (NCBI) | 5371 |
| RRID | AB_2878799 |
| 偶联类型 | Unconjugated |
| 形式 | Liquid |
| 纯化方式 | Antigen affinity purification |
| UNIPROT ID | P29590 |
| 储存缓冲液 | PBS with 0.02% sodium azide and 50% glycerol, pH 7.3. |
| 储存条件 | Store at -20°C. Stable for one year after shipment. Aliquoting is unnecessary for -20oC storage. |
背景介绍
PML, also named as MYL, RNF71 and TRIM19, is a member of RBCC/TRIM family of proteins that possess a RING finger domain, B-box, and coiled-coil domain. It functions as tumor suppressor. PML is required for normal, caspase-dependent apoptosis in response to DNA damage, FAS, TNF, or interferons. It plays a role in transcription regulation, DNA damage response, DNA repair and chromatin organization. PML plays a role in processes regulated by retinoic acid, regulation of cell division, terminal differentiation of myeloid precursor cells and differentiation of neural progenitor cells. It regulates PTEN compartmentalization through the inhibition of USP7-mediated deubiquitinylation. A large number of alternative spliced transcripts are synthesized from the PML gene, resulting in a variety of PML proteins ranging in molecular weight from 48-97 kDa (PMID:11704850). And it can be detected as 70-130 kDa or larger due to the modification (especially SUMO) (PMID: 16778193, 22438555).
实验方案
| Product Specific Protocols | |
|---|---|
| IF protocol for PML antibody 21041-1-AP | Download protocol |
| IHC protocol for PML antibody 21041-1-AP | Download protocol |
| IP protocol for PML antibody 21041-1-AP | Download protocol |
| WB protocol for PML antibody 21041-1-AP | Download protocol |
| Standard Protocols | |
|---|---|
| Click here to view our Standard Protocols |
发表文章
| Species | Application | Title |
|---|---|---|
Nucleic Acids Res mRNAs are sorted for export or degradation before passing through nuclear speckles. | ||
Theranostics Autophagic degradation of PML promotes susceptibility to HSV-1 by stress-induced corticosterone. | ||
Front Oncol Identification of a Two-Gene (PML-EPB41) Signature With Independent Prognostic Value in Osteosarcoma. | ||
J Ginseng Res 20(S)-ginsenoside Rh2 induces caspase-dependent promyelocytic leukemia-retinoic acid receptor A degradation in NB4 cells via Akt/Bax/caspase9 and TNF-α/caspase8 signaling cascades. |